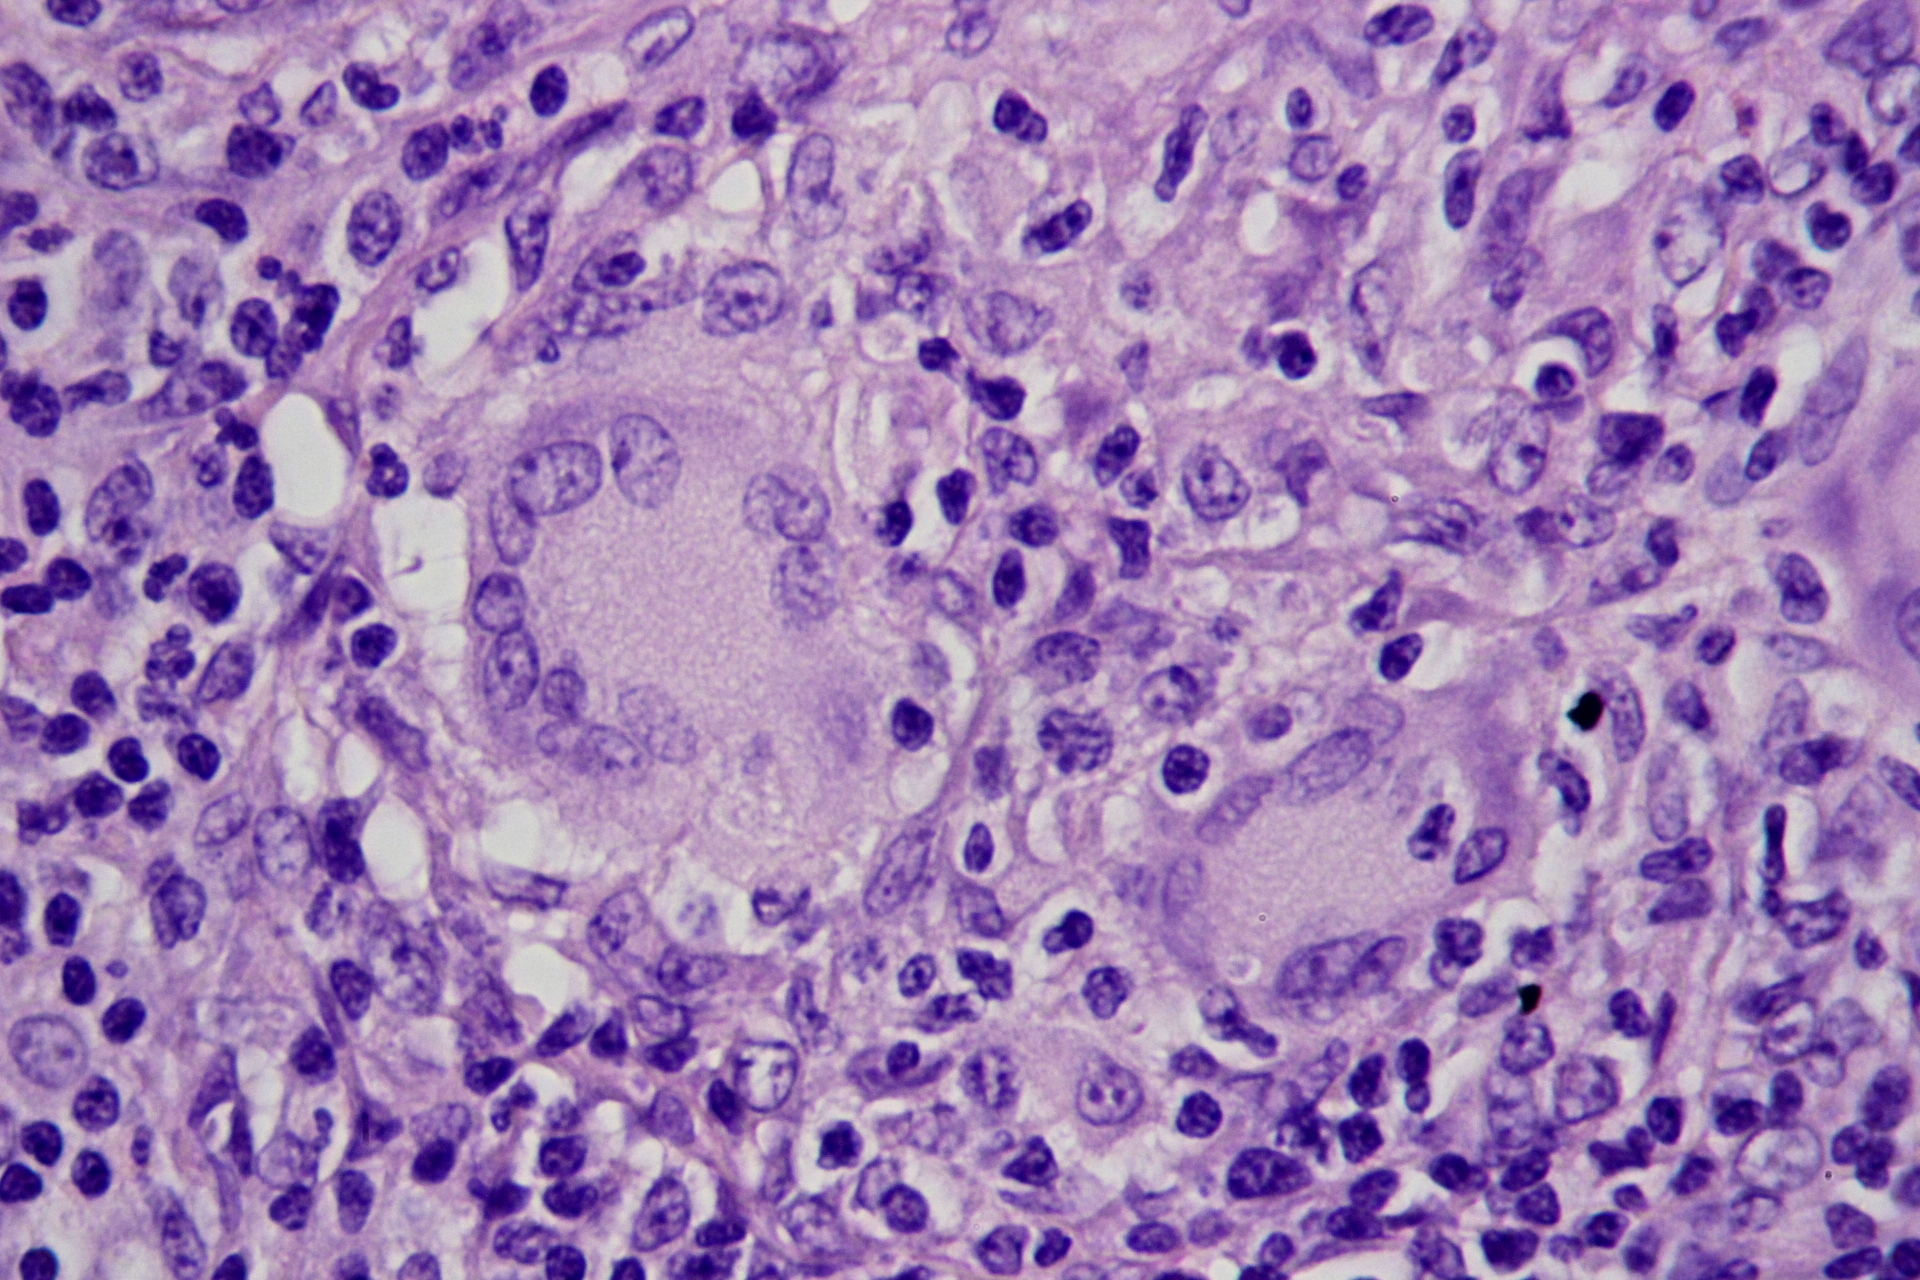
term image

Pathology of Large Intestine
1/74
Name | Mastery | Learn | Test | Matching | Spaced | Call with Kai |
|---|
No analytics yet
Send a link to your students to track their progress
75 Terms
acquired malformation of submucosal and mucosal blood vessels
often present with bright red bloos in stool
angiodysplasia
where does angiodysplasia most often occur
cecum or right colon usually after 6th decade of life
nonocclusive transient hypoperfusion, usually due to atherosclerosis in SMA or IMA
ischemic colitis
left sided abdominal pain, may result in fibrosis that can lead to stricture and obstruction
ischemic colitis
congential toxic megacolon
hirschsprung disease
congenital absence of parasympathetic ganglion cells in rectum ALWAYS and sigmoid colon often → impaired colorectal relaxation and peristalsis → obstruction
hirschsprung disease
usually sporadic but 10% have downs syndrime
familial cases with RET mutaitons
hirschsprung disease
blind pi=ouch leading of alimentary tract lined by mucosa that communicates with gut lumen
NOT a true diverticulum, aka tics
colonic diverticulum
most in sigmoid colon
lack muscularis propria, outpouching due to focal weakness and increased pressure
assoc with western diet
rare before 30
colonic diverticulitis
most common cause of lower GI bleeding
colonic diverticulosis
outpouchings in diverticulosis
can lead to infections and can also trap stool
no muscle to push it out
acute colitis with adherent inflammatory exudate overlying sites of mucosal injury
usually after what
pseudomembranous colitis
usually after BROAD SPEC ANTIBIOTICS
broad spec antibiotics favor what in gut
c diff overgrowth
yellow white or yellow green mucosal plaques or pseudomembranes
pseudomembranous colitis
tx for pseudomembranous colitis
metronidazole, vancomycin, fidamoxicin, fecal transplant
linear configurations of karyorrhectic debris and neutrophils that adheers to mucosal surface
micro of pseudomembranous colitis
two most common inflammatory bowel diseases
crohns disease and ulcerative colitis
abdominal pain and diarrhea which may be bloody, need to rule out infection and ischemia
IBD
more likely to be bloody in UC
smoking has been seen to double the risk of this
crohn disease
granulomatous colitis, GRANULOMAS KEY MICROSCOPIC FINDING
crohn disease
assoc with ankylosing spondylitis (HLA B27), migratory polyarthritis, erythema nodosum, anti saccharoymces cervisiae antibodies (ASCA)
crohn disease
most common site for crohn disease
terminal ileum
patchy transmural granulomatous inflammation affecting entire thickness of bowel wall
crohn disease
skip lesions - intervening normal areas between areas
crohn disease
right lower quadrant pain and non bloody diarrhea
malabsorption due to small bowel damage
calcium oxalate stones
increased risk of carcinoma
crohn disease
cobblestone of mucosa
strictures (String sign)
focal ulcers fissues and fistulas
thickened wall with loss of mucosal folds
creeping fat, related to fibrosis of wall
NONcaseating GRANULOMA with lymphocytes
crohn disease
multinucleated giant cell in crohn disease, granuloma
assoc with sclerosing cholangitis, positive p-ANCA
smoking protects, milk may exacerbate
ulcerative colitis
starts in rectum, doesn’t skip grows continually
left lower quadrant pain, bloody diarrhea
UC
pseuodpolyps- edematous intact mucosa next to areas of ulceration
UC
loss of haustra looks like what on imaging
lead pipe sign
UC
inflammation is not transmural, limited to mucosa and submucosa
muscularis and seroa normal
UC
toxic damage in UC may lead to what
toxic megacolon, dilation stasis and gangrene
increased risk of what in UC
carcinoma (depends on extent adn duration of disease)
what has a negative assoc with UC
appendectomies
raised red islands of inflamed mucosa. between them is only remaining muscularis
UC, pseudopolyps

micro of UC vs CD
crypt abcesses
UC
CD vs UC
CD: small bowel (terminal ileum) and right colon
patchy
transmural, fistulas, strictures, seositis
non caseating granuloma
poor resp to surg
increased risk for cancer
UC: colon only, begin at rectum
continous, not transmural
superficial inflammation
no granulomas
good resp to surg
increased risk for cancer


lead pipe sign, UC

string sign, CD
if there are fistulas in IBD then it is
crohn disease
if it involves the small intestin in IBD then it is
NOT UC
does not move oast ileocecal valve
chronic recurring and relapsing abdominal pain associated with defecation and changes in bowel habits
can be diarrhea dominant constipation dominant or mixed
rome IV diagnostic
IBS
mass that protrudes into gut lumen
polyps
pedunculated with stalk or sessile without stalk
non neoplastic not precancerous serrated (sawtooth) or star shaped appearance of crypt epithelim
hyperplastic polyps
neoplastic may become cancerous often have tubular (rounded) glands or villous (papillary projections) or serrated (sawtooth)
adenomatous polyps/adenomas
greatest risk for developing cancer (polyps)
sessile and villous
inhertied mutation in APC gene on chromosome 5.q21
atusomal dominant
thousands of polyps
100% risk for developing colon cancer by age 50
prophylactic colectomy
FAP familial polyposis syndrome, familial adeomatous polyposis
most common form of colonic polyp
hyperplastic polypf
delayed shedding of surface epithelial cells with gland hyperplasia
assoc with cigarette smoking
hyperplastic polyp
small, sessile, on top of mucosal folds, same color as surrounding
well formed elongated glands and crypts with saw tooth or star appearance
hyperplastic polyps
msot common form of neoplastic colonic polyp
adenoma
premalignant with areas of dysplasia
not all are polypoid
adenoma
which adenomas have highest rate of malignant transformation (histology)
villous histology

adneoma
benign hamartomatous polyp generally solitary and not premalignant
juvenile polyp
many juvenile polyps and increased risk of progression to adenomas and carcinomas
SMAD4 or BMPR1A mutations
most common childhood polyp
juvenile polyp
granulation tissue and ulcer covering abundant custically dilated flands filled with mucus with an edematous and inflamed stroma
juvenile polyp
STK11 mutation, median age 11
rare autosomal dominant syndrome
peutz jeghers syndrome
multiple GI hamartomatous polyps and mucocutaneous hyperpigmentation
throughout GI tract
dark blue to brown macules on lips nostrils buccal mucosa palmar surfaces of the hands genitalia and perianal region
similar to freckles but distinguished by presence in buccal mucosa
peutz jeghers syndrome
how ar peutz jeghers spots distinguished frmo freckles
presence in buccal mucosa, non sunexposed areas
peutz jeghers syndrome has marked increase risk for what
seveal malignanices
arises in colon or rectum
most commonly arises from adenomatous polyp
colorectal adenocarcinoma
autosomal dominatn inheritance, microsatellite instability
mutation of DNA mismatch repair genes leading to incorrect copying of microsatellites during cell division
HNPCC aka lynch syndrome
loss of what might enhance survival of genetically abnormal clones
BAX proapoptotic protein
lynch syndrome increased risk for
colorectal ovarian and endometrial cancer
most in RIGHT colon
more in left colon vs more in right colon
adenoma carcinoma sequence left
lynch syndrome right
asymptomatic,
right sided tumors
classically grow as raised lesion
fatigue, weakness, variable abdominal pain, occult blood in stool (melena), iron deficiency anemia
colonic adenocarcinoma
FAP or lynch plus brain tumors
turcot syndrome

napkin ring/apple core type lesions in ____ sided tumors
colonic adenocarcinoma left sided
change in stool habits, bloody stool, crampy pain, obstruction
where does colonic adenocarcinoma spread to the most
lymph nodes, liver
lungs bone
serum tumor marker for colonic adenocarcinoma
CEA carcinoembryonic antigen